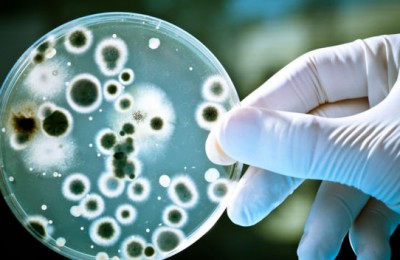

Categoría: Salud
MOCA: Podría cerrar Instituto Mocano de las Diabetes
Gregoria NuñezJun 03, 2015
RD-MOCA.- El director del Instituto Mocano de las Diabetes, doctor Adilcio Ureña, anunció que alrededor 30 mil personas padecen diabetes en la provincia Espaillat, lo...
Un niño de 8 años deja crecer su pelo durante 2 años para donarlo a enfermos de cáncer
Antonio Da SilvaJun 03, 2015
Cristina McPhilamy, de 8 años, cambió su forma de ver el mundo tras una visita al Hospital de Investigación Infantil St. Jude Children de Florida. McPhilamy se...
Ántrax activo pudo haber ido a Canadá y estado de Washington
Kenia Del OrbeJun 03, 2015
AP Washington El Pentágono llegó a la conclusión de que ántrax activo pudo haber sido enviado por error a laboratorios en Canadá y el estado de Washington, además...
Nuevas esperanzas para los hipertensos
Gregoria NuñezJun 01, 2015
Los medicamentos conocidos como inhibidores de la peptidil dipeptidasa o enzima convertidora de angiotensina (ECA), una sustancia muy vasoconstrictora y que, por tanto,...
Venezuela: Alertan sobre desplazamiento de cólera a zonas urbanas de Haití
Kenia Del OrbeJun 01, 2015
Venezuela.- Según la OCHA, el desplazamiento de los casos plantea nuevas preocupaciones ante la llegada de la temporada de lluvias que tiende a incrementar esa...
El tabaquismo provoca en Cuba unas 36 muertes cada día
Kenia Del OrbeJun 01, 2015
EFE La Habana El tabaquismo es la enfermedad no genética que más afecta la esperanza de vida de los cubanos, y cada día fallecen como promedio en el país 36 personas...
Alerta de cólera en Haití
Carmen RamirezJun 01, 2015
PUERTO PRINCIPE (PL).- Una epidemia de cólera se desplaza de las zonas rurales a las urbanas, reveló la Oficina de Naciones Unidas para la Coordinación de Asuntos...
Cómo me cambió la personalidad una lesión cerebral
Carmen RamirezJun 01, 2015
Con el objetivo de dar a conocer las consecuencias que dejan enfermedades o accidentes que ocasionan lesiones cerebrales, un blog compila las experiencias personales de...
Cómo quitarle a los niños los caprichos a la hora de comer
Carmen RamirezJun 01, 2015
Las batallas con los más pequeños a la hora de comer pueden ser un estrés para toda la familia. Es frustrante cuando pasas mucho tiempo preparando una comida y...
¿Es este el mejor método para el asado perfecto?
Carmen RamirezJun 01, 2015
Fue en Memphis, Tennessee, donde Kit Parker empezó a pensar en impartir una clase sobre barbacoa estilo estadounidense en la universidad de Harvard. El profesor de...

SEO DuckCTR Solutions
[…] SEO DuckCTR Solutions -_- SEO DuckCTR Solutions SEO DuckCTR Solutions SEO DuckCT...
tesco cheap viagra
[…] viagra professional sale […]
order generic viagra no presc...
[…] cheap viagra online […]
viagra buy over counter
[…] viagra buy paypal […]